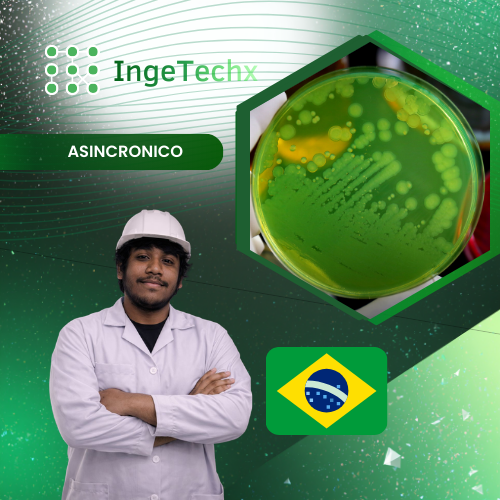
Producción de pseudomonas fluorescens

Producción de pseudomonas fluorescens
¿Qué aprenderás en este curso?
En este curso, aprenderás el potencial agrícola y biotecnológico de Pseudomonas fluorescens, un microorganismo clave en la promoción del crecimiento vegetal y en el control biológico de patógenos. Conocerás sus características fisiológicas y ecológicas, mecanismos de acción y su papel en la producción de fitohormonas, sideróforos y antibióticos. Profundizarás en técnicas de aislamiento e identificación de cepas, así como en el diseño de medios de cultivo y condiciones de fermentación para la producción de bioinsumos de calidad. También explorarás la formulación y aplicación de metabolitos antimicrobianos, junto con métodos de evaluación de eficacia en campo. Durante el curso, adquirirás habilidades prácticas para el control de parámetros críticos en el laboratorio, análisis microbiológico y evaluación de viabilidad celular. Además, conocerás experiencias reales de aplicación en agricultura, con énfasis en el impacto benéfico de Pseudomonas fluorescens sobre los cultivos y el suelo.
Metodología
- El curso se ofrece en modalidad sincrónica, lo que te permitirá participar en sesiones en vivo a través de Zoom, con la opción de visualizar las grabaciones posteriormente. Los materiales del curso estarán disponibles para descarga.
Proceso de inscripción
- Puedes inscribirte en el curso en línea a través de nuestra página web.
- También tienes la opción de adquirir el curso mediante un asesor, contactándonos por WhatsApp haciendo clic aquí.
Estado del curso
- Disponibilidad: Vacantes abiertas.
- Temario y fechas: Consulta el brochure en la parte inferior de esta página o contacta a nuestro asesor haciendo click aquí.
- Curso grabado
- Acceso por un año
- Número de módulos: 2
- Duración total: 4 horas.
- Certificación total: 12 horas.
Requisitos
- Una PC o laptop.
- Motivación para aprender y mejorar tus habilidades.
Certificación
- Al finalizar el curso, recibirás un certificado gratuito emitido por el Centro de formación en ciencias, ingeniería e idiomas S.A.C.
- También tienes la opción de obtener un certificado adicional emitido por una Universidad con la que mantenemos convenio.
Te invitamos a unirte a nuestro grupo de WhatsApp dando click aquí
Contenido del Curso
Información
$13.00 El precio original era: $13.00.$10.00El precio actual es: $10.00.